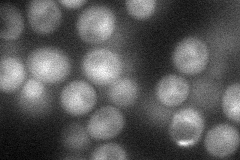
YNL223W
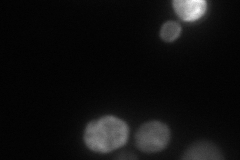
YNL223W
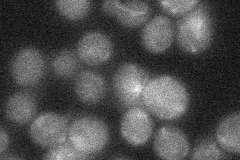
YNL223W
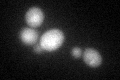
YNL223W
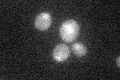
YNL223W

View description
Conserved cysteine protease required for autophagy; cleaves Atg8p to a form required for autophagosome and Cvt vesicle generation
Localization:
Intensity:
Fold change:
Significance:
-
C’ GFP library in SD

cytosol21.35 -
N' NOP1pr-GFP in SD
cytosol42.5806 -
N' TEF2pr-mCherry in SD
cytosol65.9777 -
N' NATIVEpr-GFP in SD
below threshold22.3279 -
N' TEF2pr-VC and Cyto-VN in SD

#N/A0 -
C’ GFP library in SD+DTT
cytosol28.181.31Yes -
C’ GFP library in SD+H2O2

cytosol22.341.04No -
C’ GFP library in Starvation Media
cytosol25.391.18No -
C’ GFP library on the background of Pup2-DaMP

cytosol -
C’ GFP library on the background of CCT mutant

cytosol21.82661.02218No
